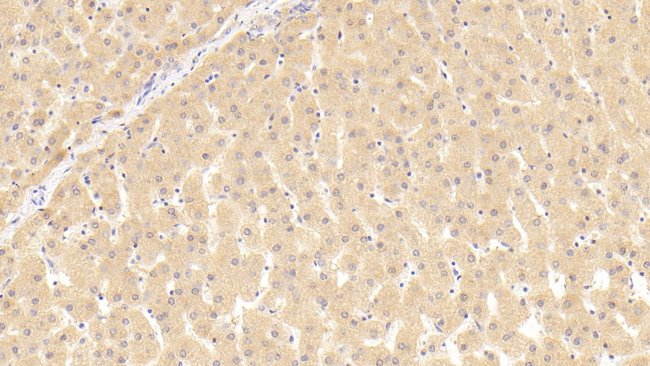
THRB Antibody in Immunohistochemistry (Paraffin) (IHC (P))

Search
Invitrogen
THRB Polyclonal Antibody
{{$productOrderCtrl.translations['antibody.pdp.commerceCard.promotion.promotions']}}
{{$productOrderCtrl.translations['antibody.pdp.commerceCard.promotion.viewpromo']}}
{{$productOrderCtrl.translations['antibody.pdp.commerceCard.promotion.promocode']}}: {{promo.promoCode}} {{promo.promoTitle}} {{promo.promoDescription}}. {{$productOrderCtrl.translations['antibody.pdp.commerceCard.promotion.learnmore']}}


Please note: We are reviewing Western blot images included in the antibody testing data in our catalog, including those provided by third parties. Unless expressly labeled or annotated as “raw-unedited”, Western blot images included in the antibody testing data in our catalog may have been edited, optimized or otherwise adjusted for presentation.
产品信息
PA5150326
种属反应
宿主/亚型
分类
类型
抗原
偶联物
形式
浓度
规格
纯化类型
保存液
内含物
保存条件
运输条件
RRID
靶标信息
Thyroid hormone receptors (TR), also known as c-erbA-2, are ligand-dependent, intracellular proteins that stimulate transcription of specific genes by binding to specific DNA sequences called hormone response elements following activation by the appropriate hormone. Thyroid hormones, through their interaction with TR, effect metabolic processes, growth and development in many tissues by regulating the expression of genes for growth hormone, malic enzyme and several hepatic proteins. There are two forms of TR; TR alpha (on chromosome 17) and TR beta (on chromosome 3). Each of these isoforms also has two isoforms; TR alpha-1 and TRv alpha-2, and TR beta-1 and TR beta-2 respectively. TR alpha-1 and 2 are identical through amino acid 370 where their sequences diverge. TRv alpha-2, which does not bind T3 and is a strong negative regulator of the functional TR, is 80 amino acids longer than TR alpha-1. The corresponding gene for the thyroid hormone receptor beta-1 is NR1A2.
仅用于科研。不用于诊断过程。未经明确授权不得转售。
篇参考文献 (0)
生物信息学
蛋白别名: c-erbA-2; c-erbA-beta; ERBA 2; ERBA BETA; ERBA-BETA; MGC126109; MGC126110; Nuclear receptor subfamily 1 group A member 2; Thyroid hormone receptor beta; TR; TR beta 1; TR-B1C-ERBA-2
基因别名: ERBA2; NR1A2; THR1; THRB
Entrez Gene ID: (Human) 7068